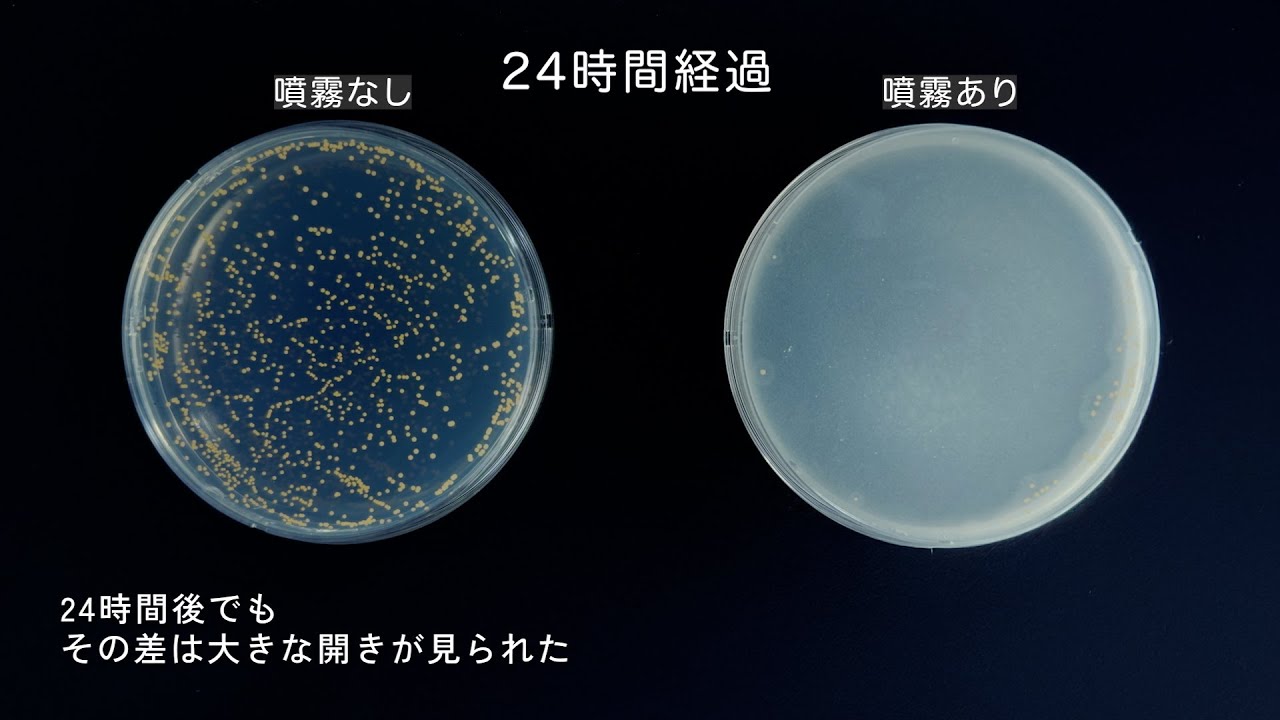
サムネイル

体のニオイ悩みは、時代とともに
変化してきました。
地球の温暖化、食生活の変化、ストレス増加や加齢など。
その原因は、さまざま。
複雑化するニオイ悩みに応え続けて24年。
私たちニオイ サイエンスLABOは、
多くの方が求める「ニオイケア効果」を
大幅強化。
研究を重ね、「防臭力」と「持続力」を
高めることで、
ニオイケアをサポート。
日常における「ニオイ悩み」からの解放をめざします。







体のニオイ悩みは、時代とともに
変化してきました。
地球の温暖化、食生活の変化、ストレス増加や加齢など。
その原因は、さまざま。
複雑化するニオイ悩みに応え続けて24年。
私たちニオイ サイエンスLABOは、
多くの方が求める「ニオイケア効果」を
大幅強化。
研究を重ね、「防臭力」と「持続力」を
高めることで、
ニオイケアをサポート。
日常における「ニオイ悩み」からの解放をめざします。